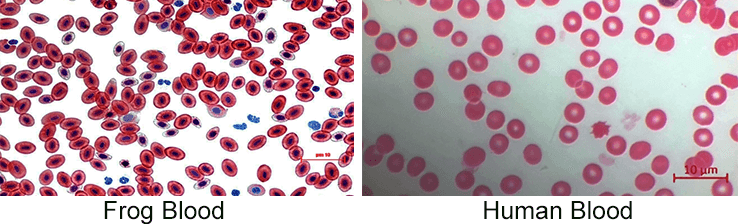
frog blood and human blood for comparison

In this hands-on microscopy lab, students investigate how blood cell structure varies across species by comparing human blood and frog blood. Using prepared blood slides, students observe red blood cells under the microscope. They document key differences in size, shape, and internal structures.
Human red blood cells are small, circular, and lack a nucleus, an adaptation that maximizes space for hemoglobin and supports the high oxygen demands of an endothermic organism. In contrast, frog red blood cells are larger, oval-shaped, and contain a nucleus.
This activity strengthens microscopy skills while reinforcing core biological concepts such as cell specialization, blood composition, and comparative anatomy. Students move beyond memorization by analyzing real biological samples. The blood samples are prepared slides, so students do not need to handle blood. I buy slides from Carolina.com and they are good quality!
Ideal for high school biology or anatomy courses, this lab encourages scientific thinking through observation, data collection, and evidence-based explanation. The lab doesn’t take very long, so I usually pair it with the lecture on blood cells. Then they head over to the lab and actually see the cells under a microscope.
Lab Handout Includes
- Directions for focusing a microscope
- Brief description of differences between frog and human blood
- Comparison chart for students to complete
- A field for sketch of frog and human blood
- Discussion questions
Related Resources
Anatomy Unit: Blood – Includes slides, worksheets, and labs for the unit
Blood Disorder Genetics – Practice Punnett squares focusing on sickle cell, and Von Willebrand disease, and Beta -thalassemia
Blood Case Studies – View slides showing blood samples and patient data to diagnose disorders
Slides: Blood Typing – students learn about blood types, blood safety, and Rh factor; designed for anatomy students

